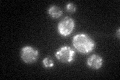
YDR376W
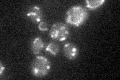
YDR376W

View description
Oxidoreductase of the mitochondrial inner membrane, involved in cytoplasmic and mitochondrial iron homeostasis and required for activity of Fe-S cluster-containing enzymes; one of the few mitochondrial proteins essential for viability
Localization:
Intensity:
Fold change:
Significance:
-
C’ GFP library in SD

mitochondria23.72 -
N' NOP1pr-GFP in SD

mitochondria100.492 -
N' TEF2pr-mCherry in SD

mitochondria4.76963 -
N' NATIVEpr-GFP in SD

missing0 -
N' TEF2pr-VC and Cyto-VN in SD

#N/A0 -
C’ GFP library in SD+DTT
mitochondria25.951.09No -
C’ GFP library in SD+H2O2

mitochondria23.080.97No -
C’ GFP library in Starvation Media
mitochondria30.041.26No -
C’ GFP library on the background of Pup2-DaMP

mitochondria -
C’ GFP library on the background of CCT mutant

mitochondria21.58470.909535No
